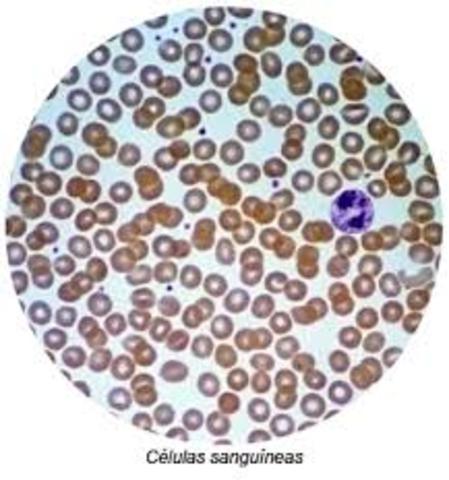
Todos los organismos vivos están compuestos por   células

-
en los primeros años de la civilización 1.000 años a.C. los babilónicos simbólicamente celebraban con ritos religiosos la polinización de las palmeras, ya que producían uno de los mas selectos alimentos de esa época: los dátiles.
-
Hipocrates: partículas especificas,son producidas por el cuerpo y se trasmite a la progenie en el momento de la concepción . haciendo que ciertas partes de la progenie se asemeje a esas misma partes de a progenie
-
con su razonamiento empírico hablaba sobre la naturaleza de la reproducción humana y sobre los aspectos de identidad, el parecido en los grupos por la herencia.
-
En la India, 100 a 300 años antes de la Era Cristiana ,existían libros de texto escritos metafóricamente sobre la naturaleza de la reproducción humana,
-
Robert Hooke descubre estructuras en forma de celdas al observar corcho bajo un rudimentario microscopio que él mismo construyó; pero no es hasta el siglo XIX que se confirma que las células son las unidades fundamentales de los organismos vivos.
-
se confirma la reproducción sexual de las plantas, la cual es generada mediante el intercambio genético. En el proceso existe unión entre los gametos y un desarrollo embrionario, el cual da lugar a un nuevo organismo
-
Con el desarrollo del microscopio Anton Leeuwenhoek logra contemplar por primera vez el esperma animal,(célula sexual masculina)
-
el fisiólogo alemán Theodor Schwann (1810-1882), publicó las investigaciones microscópicas sobre la concordancia de estructura y de desarrollo de los animales y las plantas, obra en la que presentó la idea central de que "hay un principio general de construcción para todas las producciones orgánicas y este principio de construcción es la formación de la célula".
-
se inicia el Evolucionismo cuando Darwin publica el libro “El Origen de las especies por medio de la selección natural, o la preservación de las razas preferidas en la lucha por la vida”.Este libro es el inicio de la teoría de la evolución por medio de la selección natural. Lo que significa que el medioambiente donde viven los seres vivos ofrece recursos limitados. Los organismos compiten por ellos y los que consigan adaptarse mejor al medio lograrán más recursos y se reproducirán más y mejor
-
Gregor Mendel cultivó y probó cerca de 28 000 plantas de la especie Pisum sativum (guisante). Sus experimentos le llevaron a concebir dos generalizaciones que después serían conocidas como Leyes de Mendel de la herencia o herencia mendeliana. Las conclusiones se encuentran descritas en su artículo titulado Experimentos sobre hibridación de plantas
-
El biólogo Johann Friedrich Miescher, utilizo alcohol caliente y luego una pepsina enzimática, la cual separa la membrana celular y el citoplasma de la célula, lo que se quería lograr era aislar el núcleo de la célula.Este proceso se llevo a cabo con los núcleos de las células obtenidas del pus de vendajes quirúrgicos desechados y del esperma de salmón, sometiéndolos a estos materiales y a una fuerza centrifuga para aislar a los núcleos y luego realizo un análisis químico a los núcleos.
-
Con las nuevas técnicas de coloración, Walther Flemming logra identificar los «cromosomas» —de ahí su nombre: «cuerpo colorido»—, que son los filamentos condensados de ácido desoxirribonucleico, visibles en el núcleo de las células durante la mitosis.
-
Francis Galton acuñó el término «eugenesia» para describir «la práctica de la mejora biológica de la raza humana». Poco tiempo después fundó el Laboratorio de Eugenesia Nacional —hoy Laboratorio Galton, y considerado el primer departamento de genética humana del mundo. La obra de Galton incluye, entre otras excentricidades, un estudio sobre la forma de las huellas dactilares, estadísticas sobre la eficacia de rezar y un mapa de la belleza humana en las islas británicas.
-
El biólogo August Weismann (1834-1914) comprobó que la base material de la herencia se halla en los cromosomas. Propuso una teoría que postulaba la continuidad del «plasma germinal» —los gametos— que se desarrollaban y transmitían el código genético de una generación a otra, con independencia de los cambios en el resto del cuerpo
-
El genetista holandés Hugo De Vries (1848-1935), en colaboración con otros investigadores, «redescubrieron» los hallazgos de Mendel: que cada característica —la forma del chícharo— está codificada por un par de «factores» —ahora llamados «genes»—. Los dos genes se separan durante la formación de los gametos; así, cada gameto —un grano de polen masculino o un óvulo femenino— transporta sólo un gen. En la fecundación los genes se unen y forman un sólo par.
-
En EE. UU., Thomas Hunt Morgan —con la ayuda de sus alumnos Alfred Sturtevant y Hermann Müller— descubren los cromosomas «X» y «Y», al experimentar con moscas de la fruta, de igual modo que lo hizo Mendel con los chícharos. Con ello, comprobaron que el sexo de la descendencia influía a la herencia en ciertas características.
-
El biólogo danés Wilhelm Johannsen (1857-1927) acuñó el término «gen» —que significa «dar a luz»— para describir cada porción del cromosoma que controla una característica de la herencia —fenotipo.
-
Hermann Joseph Muller publicó su descubrimiento de que los Rayos X y la luz ultravioleta podían provocar cambios hereditarios, conocidos como mutaciones. A partir de entonces, los científicos pudieron crear mutaciones en vez de esperar a que la naturaleza las produjera en forma espontánea.
-
El científico inglés Frederick Griffith, al probar nuevas técnicas para clasificar patógenos, descubre la transformación genética: los genes pueden transferirse de una cepa de bacterias a otra
-
James Watson y Francis Crick desarrollan el modelo de la molécula del ADN y prueban cómo los genes determinan la herencia.
-
El genoma humano es el genoma del Homo sapiens, es decir, la secuencia de ADN contenida en 23 pares de cromosomas en el núcleo de cada célula humana diploide. De los 23 pares, 22 son cromosomas autosómicos y un par determinante del sexo
-
Diez años después de que Watson y Crick determinaran la estructura del ADN, el código genético fue descifrado y verificado. Su solución dependió en gran medida de las investigaciones llevadas a cabo sobre otro grupo de ácidos nucleicos, los ácidos ribonucleicos (ARN). Se observó que la obtención de un polipéptido a partir del ADN se producía de forma indirecta a través de una molécula intermedia conocida como ARN mensajero (ARNm).
-
La primera molécula de ADN recombinante fue creada por Paul Berg, a comienzos de los 70. Para aquella época, los biólogos moleculares habían aprendido a alterar genes individuales, cortar y pegar pedazos de ADN de diferentes organismos y moverlos de uno a otro.
-
moléculas de cDNA se pudieron clonar por la inserción del fragmento en un plásmido. De esta manera se logró clonar el gen de la insulina humana y el de la betaglobina, entre otros genes. También se utilizó la estrategia de la síntesis química total del DNA correspondiente a la proteína que se quiere que la bacteria fabrique.
-
se crea el primer ratón transgénico (el "super ratón"), insertando el gen de la hormona del crecimiento de la rata en óvulos de ratona fecundados, en el mismo año, se produce insulina utilizando técnicas de ADN recombinante.
-
la técnica PCR, permite replicar (copiar) genes específicos con gran rapidez.
-
una oveja llamada "Dolly" 1993. Abre el primer campus en Gran Bretaña para el estudio del genoma humano
-
Debido a la amplia colaboración internacional, a los avances en el campo de la genómica, así como los avances en la tecnología computacional, un borrador inicial del genoma fue terminado en el año 2000 (anunciado conjuntamente por el expresidente Bill Clinton y el ex-primer ministro británico Tony Blair el 26 de junio de 2000), finalmente el genoma completo fue presentado en abril del 2003, dos años antes de lo esperado.
-
En marzo de 2007, se concluyó el mapa del genoma humano de los mexicanos, en el cual se menciona que los genes de la población de México son el resultado de una mezcla de 35 grupos étnicos y son distintos a los de Europa, Asia y África, menciona una nota publicada en EL UNIVERSAL.
Looking for a timeline maker?
Create timelines for projects, roadmaps, history, lessons, legal cases, and stories with Timetoast. Timetoast is a timeline maker for work, school, research, and stories.